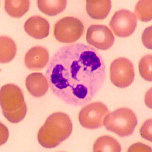

Krebsvorsorge

Die frühzeitige Erkennung von urologischen Krebserkrankungen ist von entscheidender Bedeutung für die Heilungschancen.
Je früher eine urologische Krebserkrankung erkannt wird, desto besser sind die Aussichten auf ein vollständige Heilung.
Dieses betrifft insbesondere Prostatakrebs, Nieren- und Blasenkrebs, sowie Hodenkrebs.
Deshalb ist die regelmäßige urologische Vorsorgeuntersuchung von größter Wichtigkeit.
Es wird daher Männern empfohlen – auch ohne Vorliegen von Beschwerden – einmal im Jahr eine urologische Krebsvorsorge durchführen zu lassen.
Auch Frauen sind in zunehmendem Maße von Blasen-, Harnleiter- und Nierenkrebserkrankungen betroffen. Eine regelmäßige urologische Untersuchung kann die Früherkennungsrate deutlich steigern und die Heilungschancen verbessern.
Untersuchungsmethoden

Eine gründliche, sinnvolle und dem medizinischen Kenntnisstand entsprechende, urologische Vorsorgeuntersuchung enthält unter anderem folgende Leistungen:
Ausführliche körperliche Untersuchung
Abtastung der Prostata vom Enddarm („Hamburger Hafenrundfahrt“)
Ultraschalluntersuchung von Nieren und Blase
Direkter Ultraschall der Prostata (TRUS)
Ultraschalluntersuchung auf Hodenkrebs
Blutuntersuchung
(Bestimmung der Tumormarker für Prostatakrebs [PSA] und
Hodentumoren, Hormonuntersuchung des Mannes, Kontrolle des Blutbildes und der Nierenwerte, sowie Untersuchung weiterer Parameter)
Urinuntersuchung
(Untersuchung auf Marker für Blasen- und Nierenkrebs, Nachweis von Bakterien, Pilzen und Blut im Urin, Urinzytologie)
Stuhluntersuchung
(nach Möglichkeit neuer immunologischer Stuhltest)
Private Krebsvorsorge
Die Rahmenbedingungen im deutschen Gesundheitssystem haben sich geändert.
Leider werden nicht alle im Rahmen der Krebsvorsorge zur Verfügung stehenden Untersuchungen von den gesetzlichen Kassen getragen.
Wir möchten Ihnen dennoch die bestmögliche, dem aktuellen medizinischen Kenntnisstand entsprechende, urologische Krebsvorsorge anbieten können.
Deshalb bieten wir – zusätzlich zur kassenärztlichen Behandlung - eine Reihe von privaten Vorsorgeuntersuchungen an und beraten Sie dazu auch gerne.
So können Sie selbst über den Standard Ihrer Krebsvorsorge entscheiden.
Umfangreiches Informationsmaterial ist an der Praxisanmeldung erhältlich.
Bitte sprechen Sie uns an.
Ihr Praxisteam
Weitere Informationen zur Krebsvorsorge finden Sie auch hier.
Für einige Dokumente benötigen Sie den Adobe Acrobat Reader™ , den Sie kostenlos hier herunterladen können.